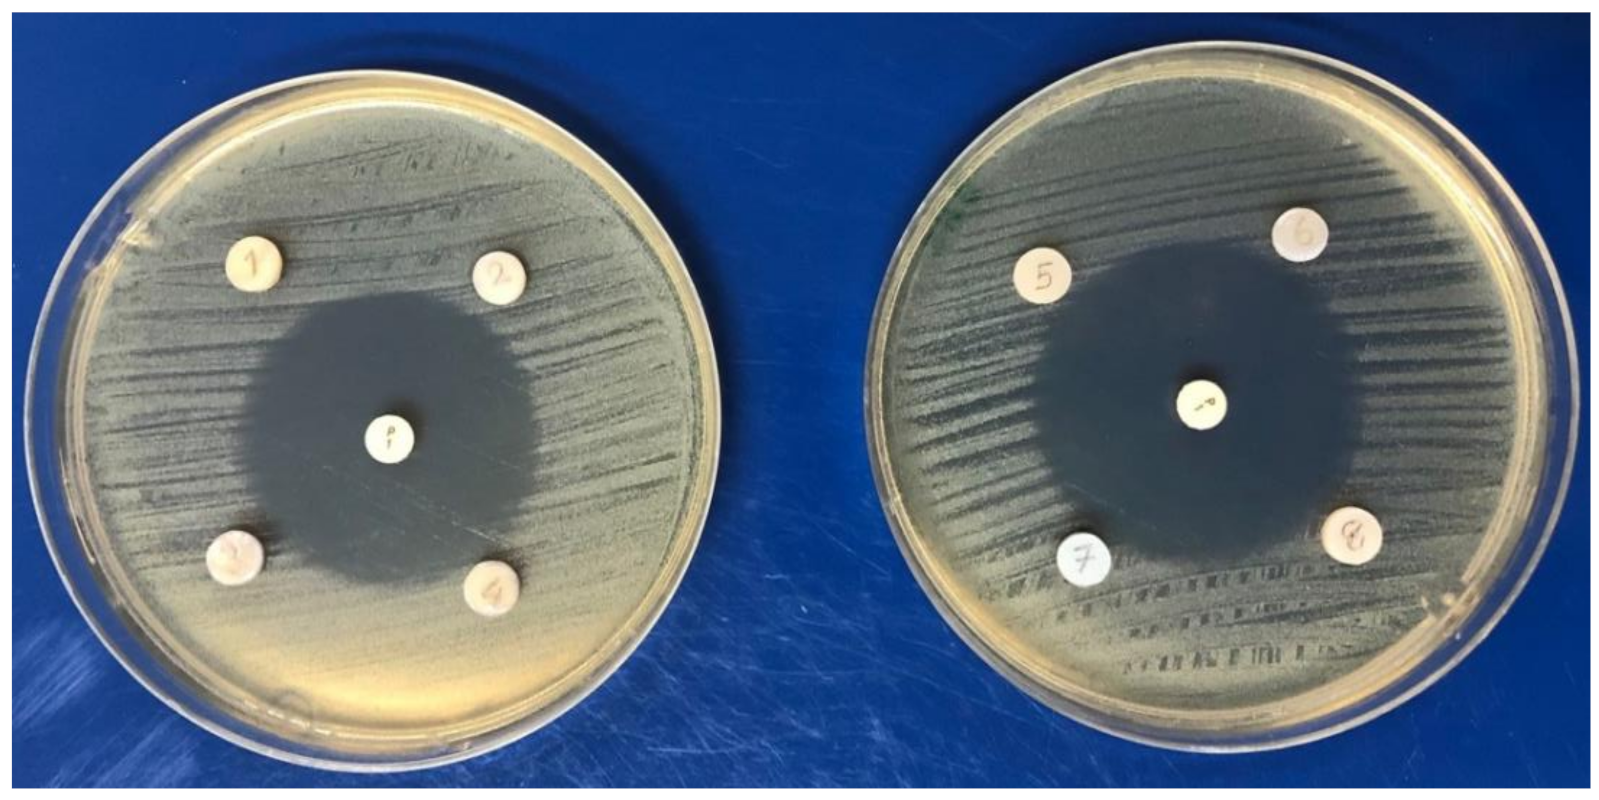
Applsci 12 02434 g002

Antibacterial Activity and Biofilm Inhibition of New-Generation Hybrid/Fluoride-Releasing Restorative Materials
Abstract
:1. Introduction
2. Materials and Methods
2.1. Sample-Size Calculation
2.2. Specimen Preparation
3. Antibacterial Activity Test
4. Biofilm Formation Assay
5. Surface Roughness (Ra) Measurement
6. Statistical Analysis
7. Results
8. Discussion
9. Conclusions
- The tested new-generation hybrid/fluoride-releasing dental materials show no antibacterial activity.
- These materials are not able to develop antibacterial properties even after treatment with additional topical fluoride.
- Biofilms accumulate to different extents on modern hybrid/fluoride-releasing restorative materials.
- This accumulation does not depend on the surface roughness of these materials.
Author Contributions
Funding
Institutional Review Board Statement
Informed Consent Statement
Data Availability Statement
Conflicts of Interest
References
- Ismail, A.I.; Hasson, H.; Sohn, W. Dental caries in the second millennium. J. Dent. Educ. 2001, 65, 953–959. [Google Scholar] [CrossRef] [PubMed]
- Puy, L.; Carmen, M. Evidence concerning the medical management of caries. Med. Oral Patol. Oral Cir. Bucal 2008, 13, E325–E330. [Google Scholar]
- Tuzuner, T.; Dimkov, A.; Nicholson, J.W. The effect of antimicrobial additives on the properties of dental glass-ionomer cements: A review. Acta Biomater. Odontol. Scand. 2019, 5, 9–21. [Google Scholar] [CrossRef] [PubMed] [Green Version]
- Beighton, D. The complex oral microflora of high-risk individuals and groups and its role in the caries process. Community Dent. Oral Epidemiol. 2005, 33, 248–255. [Google Scholar] [CrossRef] [PubMed]
- Hoszek, A.; Ericson, D. In vitro fluoride release and the antibacterial effect of glass ionomers containing chlorhexidine gluconate. Oper. Dent. 2008, 33, 696–701. [Google Scholar] [CrossRef] [Green Version]
- Dasgupta, S.; Saraswathi, M.V.; Somayaji, K.; Pentapati, K.C.; Shetty, P. Comparative evaluation of fluoride release and recharge potential of novel and traditional fluoride-releasing restorative materials: An in vitro study. J. Conserv. Dent. 2018, 21, 622–626. [Google Scholar]
- De Castilho, A.R.; Duque, C.; Negrini Tde, C.; Sacono, N.T.; de Paula, A.B.; Sacramento, P.A.; de Souza Costa, C.A.; Spolidorio, D.M.; Puppin-Rontani, R.M. Mechanical and biological characterization of resin-modified glass-ionomer cement containing doxycycline hyclate. Arch. Oral Biol. 2012, 57, 131–138. [Google Scholar] [CrossRef]
- Gurgan, S.; Kutuk, Z.B.; Ergin, E.; Oztas, S.S.; Cakir, F.Y. Clinical performance of a glass ionomer restorative system: A 6-year evaluation. Clin. Oral Investig. 2017, 21, 2335–2343. [Google Scholar] [CrossRef]
- Asmussen, E.; Peutzfeldt, A. Long-term fluoride release from a glass ionomer cement, a compomer, and from experimental resin composites. Acta Odontol. Scand. 2002, 60, 93–97. [Google Scholar] [CrossRef]
- Yi, J.; Dai, Q.; Weir, M.D.; Melo, M.A.S.; Lynch, C.D.; Oates, T.W.; Zhang, K.; Zhao, Z.; Xu, H.H.K. A nano-CaF2-containing orthodontic cement with antibacterial and remineralization capabilities to combat enamel white spot lesions. J. Dent. 2019, 89, 103172. [Google Scholar] [CrossRef]
- Garcia-Contreras, R.; Scougall-Vilchis, R.J.; Contreras-Bulnes, R.; Sakagami, H.; Morales-Luckie, R.A.; Nakajima, H. Mechanical, antibacterial and bond strength properties of nano-titanium-enriched glass ionomer cement. J. Appl. Oral Sci. 2015, 23, 321–328. [Google Scholar] [CrossRef] [Green Version]
- Tiwari, S.; Kenchappa, M.; Bhayya, D.; Gupta, S.; Saxena, S.; Satyarth, S.; Singh, A.; Gupta, M. Antibacterial activity and fluoride release of glass-ionomer cement, compomer and zirconia reinforced glass-ionomer cement. J. Clin. Diagn. Res. 2016, 10, ZC90–ZC93. [Google Scholar] [CrossRef]
- Kimyai, S.; Bahari, M.; Naser-Alavi, F.; Behboodi, S. Effect of two different tooth bleaching techniques on microhardness of giomer. J. Clin. Exp. Dent. 2017, 9, e249–e253. [Google Scholar] [CrossRef]
- Kooi, T.J.; Tan, Q.Z.; Yap, A.U.; Guo, W.; Tay, K.J.; Soh, M.S. Effects of food-simulating liquids on surface properties of giomer restoratives. Oper. Dent. 2012, 37, 665–671. [Google Scholar] [CrossRef] [Green Version]
- Botelho, M.G. Inhibitory effects on selected oral bacteria of antibacterial agents incorporated in a glass ionomer cement. Caries Res. 2003, 37, 108–114. [Google Scholar] [CrossRef]
- Herrera, M.; Castillo, A.; Bravo, M.; Liebana, J.; Carrion, P. Antibacterial activity of resin adhesives, glass ionomer and resin-modified glass ionomer cements and a compomer in contact with dentin caries samples. Oper. Dent. 2000, 25, 265–269. [Google Scholar]
- Hosida, T.Y.; Delbem, A.C.B.; Morais, L.A.; Moraes, J.C.S.; Duque, C.; Souza, J.A.S.; Pedrini, D. Ion release, antimicrobial and physio-mechanical properties of glass ionomer cement containing micro or nanosized hexametaphosphate, and their effect on enamel demineralization. Clin. Oral Investig. 2019, 23, 2345–2354. [Google Scholar] [CrossRef]
- Naik, R.G.; Dodamani, A.S.; Khairnar, M.R.; Jadhav, H.C.; Deshmukh, M.A. Comparative assessment of antibacterial activity of different glass ionomer cements on cariogenic bacteria. Restor. Dent. Endod. 2016, 41, 278–282. [Google Scholar] [CrossRef]
- Dimkov, A.; Gjorgievska, E.; Nicholson, J.W.; Kaftandzieva, A. Antibacterial effects of conventional glass ionomer cement. Bratisl. Lek. Listy 2016, 117, 31–35. [Google Scholar] [CrossRef] [Green Version]
- Herrera, M.; Castillo, A.; Baca, P.; Carrion, P. Antibacterial activity of glass-ionomer restorative cements exposed to cavity-producing microorganisms. Oper. Dent. 1999, 24, 286–291. [Google Scholar]
- Sungurtekin-Ekci, E.; Ozdemir-Ozenen, D.; Duman, S.; Acuner, I.C.; Sandalli, N. Antibacterial surface properties of various fluoride-releasing restorative materials in vitro. J. Appl. Biomater. Funct. Mater. 2015, 13, e169–e173. [Google Scholar] [CrossRef] [PubMed]
- Meiers, J.C.; Miller, G.A. Antibacterial activity of dentin bonding systems, resin-modified glass ionomers, and polyacid-modified composite resins. Oper. Dent. 1996, 21, 257–264. [Google Scholar] [PubMed]
- Souza, J.C.; Mota, R.R.; Sordi, M.B.; Passoni, B.B.; Benfatti, C.A.; Magini, R.S. Biofilm formation on different materials used in oral rehabilitation. Braz. Dent. J. 2016, 27, 141–147. [Google Scholar] [CrossRef]
- Luczaj-Cepowicz, E.; Marczuk-Kolada, G.; Zalewska, A.; Pawinska, M.; Leszczynska, K. Antibacterial activity of selected glass ionomer cements. Postepy Hig. Med. Dosw. 2014, 68, 23–28. [Google Scholar] [CrossRef] [PubMed]
- Yesilyurt, C.; Er, K.; Tasdemir, T.; Buruk, K.; Celik, D. Antibacterial activity and physical properties of glass-ionomer cements containing antibiotics. Oper. Dent. 2009, 34, 18–23. [Google Scholar] [CrossRef] [PubMed] [Green Version]
- Hahnel, S.; Ionescu, A.C.; Cazzaniga, G.; Ottobelli, M.; Brambilla, E. Biofilm formation and release of fluoride from dental restorative materials in relation to their surface properties. J. Dent. 2017, 60, 14–24. [Google Scholar] [CrossRef] [PubMed]
- Wongpraparatana, I.; Matangkasombut, O.; Thanyasrisung, P.; Panich, M. Effect of vital tooth bleaching on surface roughness and streptococcal biofilm formation on direct tooth-colored restorative materials. Oper. Dent. 2018, 43, 51–59. [Google Scholar] [CrossRef]
- Duque, C.; Negrini Tde, C.; Hebling, J.; Spolidorio, D.M. Inhibitory activity of glass-ionomer cements on cariogenic bacteria. Oper. Dent. 2005, 30, 636–640. [Google Scholar]
- Scherer, W.; Lippman, N.; Kaim, J. Antimicrobial properties of glass-ionomer cements and other restorative materials. Oper. Dent. 1989, 14, 77–81. [Google Scholar]
- Vermeersch, G.; Leloup, G.; Delmee, M.; Vreven, J. Antibacterial activity of glass-ionomer cements, compomers and resin composites: Relationship between acidity and material setting phase. J. Oral Rehabil. 2005, 32, 368–374. [Google Scholar] [CrossRef]
- Lewinstein, I.; Matalon, S.; Slutzkey, S.; Weiss, E.I. Antibacterial properties of aged dental cements evaluated by direct-contact and agar diffusion tests. J. Prosthet. Dent. 2005, 93, 364–371. [Google Scholar] [CrossRef]
- Perez, C.R.; Hirata, R., Jr.; Sergio, P.P. Evaluation of antimicrobial activity of fluoride-releasing dental materials using a new in vitro method. Quintessence Int. 2003, 34, 473–477. [Google Scholar]
- Boeckh, C.; Schumacher, E.; Podbielski, A.; Haller, B. Antibacterial activity of restorative dental biomaterials in vitro. Caries Res. 2002, 36, 101–107. [Google Scholar] [CrossRef]
- DeSchepper, E.J.; White, R.R.; von der Lehr, W. Antibacterial effects of glass ionomers. Am. J. Dent. 1989, 2, 51–56. [Google Scholar]
- Ariffin, Z.; Ngo, H.; McIntyre, J. Enhancement of fluoride release from glass ionomer cement following a coating of silver fluoride. Aust. Dent. J. 2006, 51, 328–332. [Google Scholar] [CrossRef] [Green Version]
- Hsu, H.M.; Huang, G.F.; Chang, H.H.; Wang, Y.L.; Guo, M.K. A continuous flow system for assessing fluoride release/uptake of fluoride-containing restorative materials. Dent. Mater. 2004, 20, 740–749. [Google Scholar] [CrossRef]
- Hotwani, K.; Thosar, N.; Baliga, S.; Bundale, S.; Sharma, K. Antibacterial effects of hybrid tooth colored restorative materials against Streptococcus mutans: An in vitro analysis. J. Conserv. Dent. 2013, 16, 319–322. [Google Scholar] [CrossRef]
- Naoum, S.; Ellakwa, A.; Martin, F.; Swain, M. Fluoride release, recharge and mechanical property stability of various fluoride-containing resin composites. Oper. Dent. 2011, 36, 422–432. [Google Scholar] [CrossRef]
- Ionescu, A.; Brambilla, E.; Hahnel, S. Does recharging dental restorative materials with fluoride influence biofilm formation? Dent. Mater. 2019, 35, 1450–1463. [Google Scholar] [CrossRef]
- Dutra, D.; Pereira, G.; Kantorski, K.Z.; Valandro, L.F.; Zanatta, F.B. Does finishing and polishing of restorative materials affect bacterial adhesion and biofilm formation? A systematic review. Oper. Dent. 2018, 43, E37–E52. [Google Scholar] [CrossRef]
- Anami, L.C.; Pereira, C.A.; Guerra, E.; Assuncao e Souza, R.O.; Jorge, A.O.; Bottino, M.A. Morphology and bacterial colonisation of tooth/ceramic restoration interface after different cement excess removal techniques. J. Dent. 2012, 40, 742–749. [Google Scholar] [CrossRef]
- Hannig, C.; Hannig, M.; Rehmer, O.; Braun, G.; Hellwig, E.; Al-Ahmad, A. Fluorescence microscopic visualization and quantification of initial bacterial colonization on enamel in situ. Arch. Oral Biol. 2007, 52, 1048–1056. [Google Scholar] [CrossRef] [PubMed]
- Wang, S.P.; Ge, Y.; Zhou, X.D.; Xu, H.H.; Weir, M.D.; Zhang, K.K.; Wang, H.H.; Hannig, M.; Rupf, S.; Li, Q.; et al. Effect of anti-biofilm glass-ionomer cement on Streptococcus mutans biofilms. Int. J. Oral Sci. 2016, 8, 76–83. [Google Scholar] [CrossRef] [Green Version]
- Bollen, C.M.; Lambrechts, P.; Quirynen, M. Comparison of surface roughness of oral hard materials to the threshold surface roughness for bacterial plaque retention: A review of the literature. Dent. Mater. 1997, 13, 258–269. [Google Scholar] [CrossRef]
- Song, F.; Koo, H.; Ren, D. Effects of Material Properties on Bacterial Adhesion and Biofilm Formation. J. Dent. Res. 2015, 94, 1027–1034. [Google Scholar] [CrossRef] [PubMed]
- Anselme, K.; Davidson, P.; Popa, A.M.; Giazzon, M.; Liley, M.; Ploux, L. The interaction of cells and bacteria with surfaces structured at the nanometre scale. Acta Biomater. 2010, 6, 3824–3846. [Google Scholar] [CrossRef] [PubMed]

| Material | Material Type | Composition | Manufacturer |
|---|---|---|---|
| G-aenial A’Chord | Nano hybrid resin composite | Bis-MEPP, Filler load: 82% by weight: glass-filler (300 nm barium glass) 16 nm (fumed silica), organic filler (300 nm barium glass; 16 nm fumed silica). | GC Corp., Tokyo, Japan |
| Equia Forte HT Fil | Bulk-fill glass hybrid | Fluoroaluminosilicate glass, polyacrylic acid, iron oxide polybasic carboxylic acid, water | GC Corp., Tokyo, Japan |
| Riva Self-Cure | Bulk-fill glass hybrid | Strontium Fluoro-aluminosilicate glass, polyacrylic acid copolymer powders, pigment, polyacrylic acid copolymer, tartaric acid | SDI, Victoria, Australia |
| Zirconomer | Zirconia-reinforced glass ionomer | Alumino-fluoro-silicate glass, zirconium oxide, tartaric acid, polyacrylic acid, deionized water | Shofu INC, Kyoto, Japan |
| Beautifil II | Giomer | Bis-GMA 7.5%, triethylenglycol dimethacrylate 5%, aluminofluoro-borosilicate glass 7.5%, Al2O3, DL-camphorquinone | Shofu Dental, Kyoto, Japan |
| Riva Silver | Silver-reinforced glass ionomer | Polyacrylic acid, tartaric acid, balancing component, alloy powder | SDI, Victoria, Australia |
| Equia Forte coat | Light-cured resin coating | Urethane methacrylate, methyl methacrylate, camphorquinone, colloidal silica, phosphoricester monomer | GC Corp., Tokyo, Japan |
| MI Paste Plus Strawberry | Topical crème with calcium, phosphate, and fluoride | Pure water, glycerol, CPP-ACP, D-sorbitol, CMC-Na, propylene glycol, silicon dioxide, titanium dioxide, xylitol, phosphoric acid, sodium fluoride, flavoring, sodium saccharin, ethyl p-hydroxybenzoate, propyl, p-hydroxybenzoate, butyl p-hydroxybenzoate | GC Corp., Tokyo, Japan |
| Materials | Mean ± SD | Median | Min–Max | p |
|---|---|---|---|---|
| G-aenial A’Chord | 0.096 ± 0.020 ab | 0.105 | 0.057–0.109 | <0.005 |
| Equia Forte HT Fil without coating | 0.056 ± 0.031 a | 0.070 | 0.011–0.087 | |
| Equia Forte HT Fil with coating | 0.019 ± 0.014 a | 0.012 | 0.005–0.042 | |
| Riva Self-Cure without coating | 0.226 ± 0.078 b | 0.217 | 0.151–0.352 | |
| Riva Self-Cure with coating | 0.081 ± 0.057 ab | 0.081 | 0.019–0.192 | |
| Zirconomer | 0.202 ± 0.068 b | 0.202 | 0.070–0.269 | |
| Beautifil II | 0.110 ± 0.038 ab | 0.099 | 0.070–0.183 | |
| Riva Silver | 0.127 ± 0.082 ab | 0.114 | 0.057–0.295 |
| Materials | Mean ± SD | Median | Min–Max | p |
|---|---|---|---|---|
| G-aenial A’Chord | 0.163 ± 0.123 a | 0.240 | 0.090–0.469 | <0.005 |
| Equia Forte HT Fil without coating | 0.591 ± 0.302 b | 0.490 | 0.206–1.005 | |
| Equia Forte HT Fil with coating | 0.586 ± 0.305 b | 0.558 | 0.300–1.201 | |
| Riva Self-Cure without coating | 1.353 ± 0.309 c | 1.353 | 0.734–1.662 | |
| Riva Self-Cure with coating | 1.260 ± 0.341 c | 1.260 | 0.896–1.918 | |
| Zirconomer | 1.534 ± 0.250 c | 1.649 | 1.206–1.801 | |
| Beautifil II | 0.455 ± 0.182 b | 0.480 | 0.174–0.653 | |
| Riva Silver | 1.713 ± 0.273 c | 1.713 | 1.358–2.130 |
Publisher’s Note: MDPI stays neutral with regard to jurisdictional claims in published maps and institutional affiliations. |
© 2022 by the authors. Licensee MDPI, Basel, Switzerland. This article is an open access article distributed under the terms and conditions of the Creative Commons Attribution (CC BY) license (https://creativecommons.org/licenses/by/4.0/).
Share and Cite
Gurgan, S.; Vural, U.K.; Atalay, C.; Tassery, H.; Miletic, I.; Gurpinar, S.S. Antibacterial Activity and Biofilm Inhibition of New-Generation Hybrid/Fluoride-Releasing Restorative Materials. Appl. Sci. 2022, 12, 2434. https://doi.org/10.3390/app12052434
Gurgan S, Vural UK, Atalay C, Tassery H, Miletic I, Gurpinar SS. Antibacterial Activity and Biofilm Inhibition of New-Generation Hybrid/Fluoride-Releasing Restorative Materials. Applied Sciences. 2022; 12(5):2434. https://doi.org/10.3390/app12052434
Chicago/Turabian StyleGurgan, Sevil, Uzay Koc Vural, Cansu Atalay, Herve Tassery, Ivana Miletic, and Suna Sibel Gurpinar. 2022. "Antibacterial Activity and Biofilm Inhibition of New-Generation Hybrid/Fluoride-Releasing Restorative Materials" Applied Sciences 12, no. 5: 2434. https://doi.org/10.3390/app12052434
APA StyleGurgan, S., Vural, U. K., Atalay, C., Tassery, H., Miletic, I., & Gurpinar, S. S. (2022). Antibacterial Activity and Biofilm Inhibition of New-Generation Hybrid/Fluoride-Releasing Restorative Materials. Applied Sciences, 12(5), 2434. https://doi.org/10.3390/app12052434

